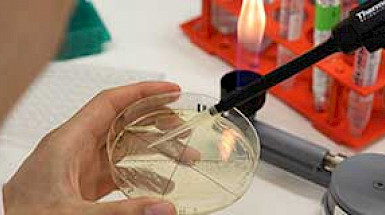

Temas: Archivo de noticias
Encuentra las noticias de archivo producidas en la UC.

Festival de Música Contemporánea del IMUC estrenó en Latinoamérica obra que duró 79 horas
Paralelo a los conciertos del festival, la obra ASLSP de John Cage fue interpretada por 65 músicos en el órgano del Templo Mayor del Campus Oriente. Asimism…

Encuentro de Diálogo Interreligioso celebró veinte años
Representantes del cristianismo, judaísmo, islamismo y budismo se reunieron para conversar acerca de la justicia y la misericordia.

Conoce las temáticas del primer Congreso de Psicología Comunitaria
La instancia que reunió a académicos UC y más de 40 estudiantes de la Escuela de Psicología fue organizada por la Sociedad Chilena de Psicología Comunitaria.

Rector visita University College London para fortalecer lazos y potenciar nuevas áreas de colaboración
Además de estrechar los vínculos académicos posteriores al Brexit, las autoridades de ambas instituciones evaluaron las posibilidades de fortalecer una mayor…

Concurso de Fundación Copec-UC premia innovaciones científicas que impactan social y económicamente
Los ganadores fueron un biocontrolador contra la marea roja; un test de saliva para la cuantificación de niveles de colesterol y glucosa; un biofunguicida de…

Egresa primera generación del diplomado en Literaturas Emergentes
Se llevó a cabo la ceremonia de titulación del programa de la Facultad de Educación que dirige la profesora de Educación UC Maili Ow, y que aborda las nuevas…

¿Cómo impacta el presupuesto en la calidad de las universidades?
Para el rector Ignacio Sánchez, el presupuesto de educación superior debe focalizar los recursos con la mirada puesta en la calidad y equidad, “de otra manera…

Comunidad de Til Til tiene nueva capilla gracias al compromiso de Derecho UC
La capilla fue construida gracias a la donación del fallecido abogado y profesor Alejandro Silva Bascuñán y el Cristo fue un aporte de la comunidad de la…

Médicos UC promueven banco de leche materna en el día del prematuro
La Corporación del Prematuro, formada por médicos UC, posee el único banco de leche materna de Chile. Ubicado en el hospital Sótero del Río, brinda la…

UC distingue a dos profesoras con el premio EdUCiencias 2016
Roxana Nahuelcura, del Liceo 1 Javiera Carrera y María Ester Penela, del Internado Nacional Barros Arana, recibieron un reconocimiento por su excelencia…

Programa Adulto Mayor UC recibe premio Plenus 2016
El PAM, con casi treinta años de trayectoria, recibió este reconocimiento que destaca aquellos proyectos que han demostrado tener una preocupación especial por…
Universidad Católica proyecta el desarrollo de la ciencia y la tecnología para resolver problemas reales de la sociedad
En palabras del rector Ignacio Sánchez, el plan es realizar investigación de excelencia, docencia, extensión y vinculación con la sociedad para contribuir al…